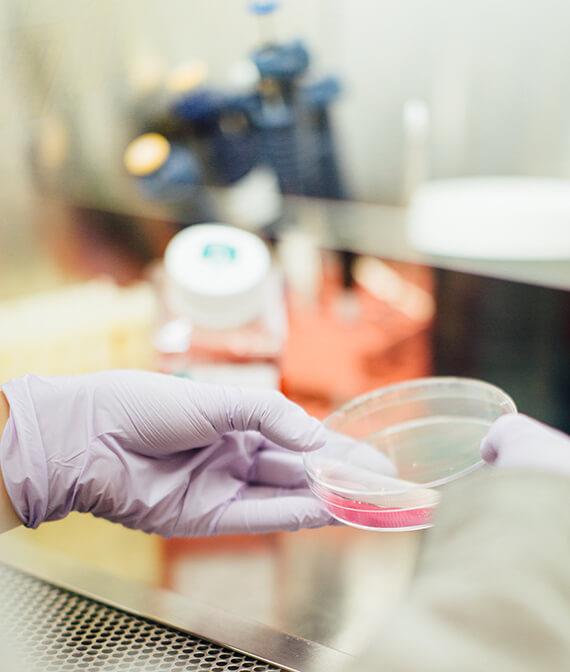

Lerochem Announces New Products & Growth In The European Chemicals Market
Lerochem, a leading supplier of specialty chemical products, proudly announces its recognition as an A-Class Leader in its category and industry, further solidifying its reputation for excellence in the European market. The company was also recently honored with the prestigious European Business Masters Award, underscoring its commitment to quality, innovation, and customer-focused solutions.
Operating with a strong focus on the EU market, Lerochem differentiates itself by offering unique chemical products while also providing flexibility in order sizes. This approach creates a win-win situation for companies looking to conduct production trials or purchase smaller quantities without compromising on quality or reliability.
To better serve R&D teams and mid-sized manufacturers, Lerochem offers rapid quotations, transparent lead times, and access to sample quantities for lab and pilot-scale testing. Its portfolio spans high-performance additives, intermediates, and niche raw materials used in coatings, plastics, water treatment, agrochemicals, and metalworking. Located in Klaipėda, the company leverages port proximity and EU-wide carrier partnerships to ship quickly and cost-effectively across the world. All sourcing adheres to REACH and CLP requirements, and customers receive batch-level documentation, safety data sheets, and technical support on request.
“Lerochem is proud to receive these significant recognitions,” said CEO at Lerochem.“The mission has always been to provide innovative, high-quality chemical solutions to European businesses of all sizes, and these achievements highlight Lerochem's long-term vision for growth and leadership.”
With its recent awards and certifications, Lerochem continues to build on its strong foundation and is committed to further expanding its reach across Europe, while maintaining its dedication to customer success and sustainable development.
About Lerochem
Lerochem is a trusted European supplier of various chemicals by classification and by usage , known for its unique product portfolio and customer-focused approach. Certified as an A-Class Leader in its industry, the company has also been recognized with the European Business Masters Award. By offering both large and small quantity orders, Lerochem supports businesses in testing, scaling, and innovating their production processes.
Lerochem's consultative sales model pairs technical specialists with purchasing teams to recommend suitable alternatives, optimize formulations, and reduce total cost-in-use. The company maintains safety stock for repeat customers to enable just-in-time deliveries, minimize downtime during trials and ramp-ups, and ensure continuity of supply during volatile market conditions.
For more information, visit:

Legal Disclaimer:
MENAFN provides the
information “as is” without warranty of any kind. We do not accept
any responsibility or liability for the accuracy, content, images,
videos, licenses, completeness, legality, or reliability of the information
contained in this article. If you have any complaints or copyright
issues related to this article, kindly contact the provider above.
Most popular stories
Market Research

- Seoul Exchange, One Of Only Two Licensed Platforms For Unlisted Securities, Will Exclusively Use Story To Settle Tokenized Rwas
- Phase 6 Reaches 50% Mark As Mutuum Finance (MUTM) Approaches Next Price Step
- 0G Labs Launches Aristotle Mainnet With Largest Day-One Ecosystem For Decentralized AI
- Solotto Launches As Solana's First-Ever Community-Powered On-Chain Lottery
- Kintsu Launches Shype On Hyperliquid
- Blockchainfx Raises $7.24M In Presale As First Multi-Asset Super App Connecting Crypto, Stocks, And Forex Goes Live In Beta





















Comments
No comment